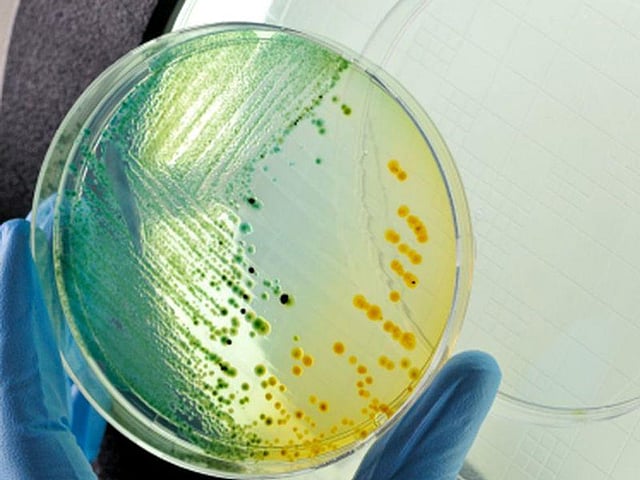

listeria outbreak 2022
7 2022 711 pm. The FDA has linked six cases of listeria from 2017 to 2022 to a strain found in samples taken at Old Europe Cheeses Michigan facility though the companys products were.
 |
| Listeria Outbreak 2022 And Symptoms To Watch Out For Fortune |
Epidemiological and laboratory data collected from sick peoples samples during the period of Oct.
. 2 days agoFor a Listeria monocytogenes outbreak from Brie and Camembert cheese an Outbreak Advisory was issued on Sept. Health officials said at least one death and a pregnancy loss are tied to an outbreak of listeria food poisoning associated with sliced deli. A total of six people infected with the outbreak strain of Listeria were reported from six states. One person has died and 13 have been hospitalized in a listeria outbreak across six states that most likely was caused by contaminated deli meat.
Deli meats cold cuts. Sick peoples samples were collected from August 6 2017 to August 5 2022. A 2015 listeria outbreak tied to ice. August 4 2022 The FDA along with CDC is assisting the Florida Department of Health FL DOH and Florida Department of Agriculture Consumer Services FDACS in.
Centers for Disease Control. 10 2022 1001 am. Sick peoples samples were. If you are in any of these groups do not eat meat or cheese from any deli counter unless it is reheated to an internal temperature of 165F.
8 2022 confirmed that enoki mushrooms contaminated with Listeria. 1 day agoThe Centers for Disease Control and Prevention CDC is continuing to investigate a Listeria outbreak linked to meat and cheese bought at deli counters. 29 2022 according to the CDC. Deadly listeria outbreak in 6 states linked to deli meat and cheese Even with adequate antibiotic treatment the disease has a high mortality rate of 20 to 30 the US.
Recall information was updated on Oct. Their ages ranged from 38 to 92. Epidemiologic Data As of November 9 2022 16 people infected with the outbreak strain of Listeria have been reported from 6 states see map. AP A nationwide listeria outbreak.
Samples from sick people were collected from April 17 2021 to Sept. A deadly outbreak of listeria in six states including Massachusetts has been linked to contaminated deli meat and cheese the US. The Centers for Disease Control and Prevention CDC is continuing to investigate a Listeria outbreak linked to meat and cheese bought at deli counters. 9 2022 652 pm.
On Wednesday Nov. David Propper November 9 2022 1102pm Updated A Listeria outbreak in the US has affected at least six states including New York. Deli meats cold cuts. A multi-state outbreak of listeria linked to deli meats and cheeses has been reported by the Centers for Disease Control and Prevention.
Posted November 9 2022 Listeria is especially harmful if you are pregnant aged 65 or older or have a weakened immune system. LOS ANGELES As has happened each December Covid-19 cases are ratcheting up in Los Angeles County with hospitalizations nearly tripling in.
 |
| Usa Old Europe Cheese Listeria Outbreak Holds At Six Sick In Six States Foodworld |
 |
| Listeria Outbreak Tied To Deli Meat Cheese Reaches California Los Angeles Times |
 |
| More Illnesses Reported From Listeria Outbreak Tied To Ice Cream Maker |
 |
| Cdc Kansas Included In Listeria Outbreak Linked To Ice Cream |
 |
| Listeria Outbreak Linked To Florida Based Ice Cream Wpec |
Posting Komentar untuk "listeria outbreak 2022"